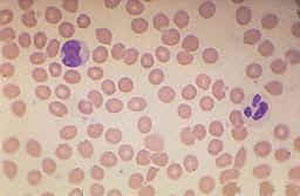

|
Dieses Beispiel zeigt einen der seltenen Fälle von Mononukleose, die primär als akute Hepatitis mit Ikterus ohne Pharyngitis, Lymphadenopathie oder andere Symptome imponieren.
Es sind IgG und IgM - Antikörper gegen "early antigen" vorhanden bei gleichzeitig (noch) negativen Antikörpern gegen "Epstein-Barr nuclear antigen 1" (EBNA-1). Dies ist typisch für eine kürzlich erworbene EBV-Infektion.
Wichtige Hinweise auf eine infektiöse Mononukleose findet man im Differenzialblutbild in Form der deutlichen Lymphozytose mit den atypischen Lymphozyten. Auch der wenig sensitive "Mononukleose Schnelltest", der seit diesem Jahr nicht mehr zu den kassenpflichtigen Laborleistungen gehört, erlaubt (wenn er positiv ist) bei passender Klinik, jungem Alter des Patienten und einem kompatiblen Blutbild die "kostengünstige" Diagnose einer infektiösen Mononukleose. Im vorliegenden Fall jedoch verzichtete der Hausarzt sowohl auf das Blutbild wie auch auf eine EBV-Serologie, weil die typischen Symptome einer Mononukleose fehlten. Dies führte etwas ins "diagnostische Abseits", was aber für den Patienten – retrospektiv gesehen - kaum von Nachteil war. |
|